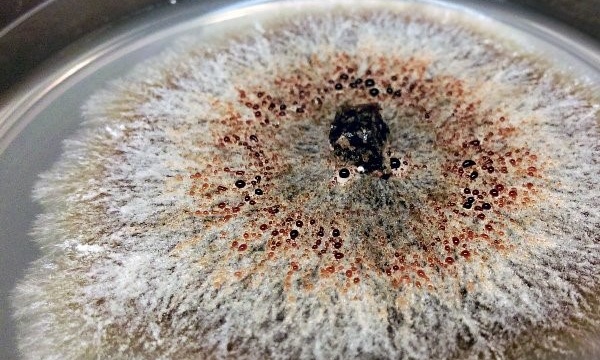

Современные способы борьбы с пластиком: грибки, переработка, восковые черви
В нашей жизни так много пластика! Мы открываем и выбрасываем бутылку молока или шампуня, забываем пользоваться многоразовыми пакетами в магазине и покупаем новый. И мало кого заботит, как все это будет разлагаться или перерабатываться. Хорошо, что наука не стоит на месте и даже делает прорывы в области переработки пластика.
Почему пластик – проблема
Почему пластик так долго разлагается и куда вообще девается? Каждую минуту в мировой океан сбрасывается содержимое одного мусоровоз. Около 7 миллиардов из 9,2 миллиарда тонн пластика, созданного с 1950 по 2017 годы, превратились в отходы на свалках. А жители планеты продолжают использовать его в быту, производя каждый год дополнительно по 1,3 млрд тонн.
Все это не проходит бесследно для океана. Запутавшись в пластиковых пакетах и мусоре, погибают черепахи, рыбы, киты мучительно умирают из-за непереваренных пластиковых отходов в желудках. Частицы микропластика находятся повсюду. Питьевая вода не исключение. И это только начало, ведь загрязнения не останавливаются.
Источник: f-musor.ru
Страдает и экономика, поскольку загрязненный океан уже не приносит прежнего дохода, а ежегодные потери составляют примерно 2,5 млрд долларов.
Человечество всерьез задумалось над этой проблемой и стало изобретать все новые способы переработки и утилизации вредного материала.
Какие способы утилизации уже есть
Начнем с раздельного сбора мусора. Как ни странно, но этот простой прием один из самых действенных: он помогает проще перерабатывать отходы, поскольку не требует дополнительной сортировки. Поэтому не игнорируйте контейнеры для раздельного сбора мусора рядом с домом.
Сжигать пластик не рекомендуется, поскольку он выделяет в атмосферу опасные канцерогены, что крайне опасно для здоровья человека и окружающей среды в целом.
Существует масса способов переработки пластика (кроме смешанного): от физического до химического. Дальше из переработанного пластика делают упаковки для косметики, корма для животных и упаковку для кофе. Но проблему это не решает — завалы пластика на свалках не исчезают, а только растут.
Источник: f-musor.ru
Что придумала сама природа
Природа настолько устала от постоянного вмешательства в ее работу, что решила сама исправить ошибки своих неразумных детей. Один из таких способ улучшения ситуации – восковые черви.
Личинка восковой моли может разлагать пластик. Суперспособность была случайно обнаружена молекулярным биологом и пчеловодом-любителем Федерикой Бертоккини. Она хотела разместить червей в пластиковый пакет для своего эксперимента. Но уже через 40 минут в нем появились дыры, а через 12 часов сотня личинок съели 92 миллиграмма пластика. Это подтолкнуло ученых заняться изучением данного вида.
Источник: meta.ua
Оказалось, что в слюне червя есть ферменты, которые разрывают длинные углеводородные цепи пластика на небольшие окисленные цепи. Эти ферменты назвали «Деметра» и «Церера» в честь древнегреческих и римских богинь земледелия, они способны разлагать пластик за короткое время и при комнатной температуре. Ученые планируют смешивать их с водой и в этой смеси растворять пластиковые отходы.
А ученые из Университета Квинсленда обнаружили подобные свойства у личинок жуков-чернотелок (Zophobas morio).
Для эксперимента разделили личинок на три группы. Первую кормили отрубями, вторую – полистиролом, а третью не кормили вообще. Выяснилось, что вторая группа выжила на необычной диете, смогла вырасти и завершить свой жизненный цикл. Но в их кишечнике было полно патогенов, а значит, особям было непросто. Чтобы облегчить их жизнь, нужно подмешивать к полистиролу и биопродукты.
Источник: nia.eco
Грибки
Ученые из Сиднея пошли еще дальше. Они обнаружили штаммы микроскопических грибков видов Aspergillus terreus и Engyodontium album, которые могут разложить пластик всего за 140 дней. Они универсальны, а их ферменты необычайно мощны. Пластик специфичен своей необычной кристаллической решеткой со множественными боковыми цепями. И чем больше ответвлений, тем сложнее вид. Поэтому смешанные типы пластика переработать почти невозможно. Грибки же расщепляют пластик на более простые молекулы, а затем поглощают их.
Ученые уже заинтересовались этой способностью и работают над прототипом этой способности. Совсем скоро мы можем увидеть ее использование в глобальных промышленных масштабах.
Источник: xage.ru
Лекарства из пластика
Причиной появления таких препаратов стали все те же грибки. Химики из Университета Южной Калифорнии с помощью химических катализаторов и кислорода под давлением разбили образцы пластикового мусора, чтобы получить химические группы, называемые двухосновными кислотами. Эти кислоты вводили в штаммы грибка Aspergillus niduluns, который легко выращивается в условиях лаборатории. В итоге переработки грибки выделяли антибиотики, статины (понижают холестерин в крови), иммунодепрессанты и даже противогрибковые препараты.
Самое удивительное, что такой способ наименее затратный и довольно простой. Так что теперь ведется работа над дальнейшим изучением.
Читайте больше на нашем сайте и не беспокойтесь о времени, ведь его вам выделят специалисты Феникс.Хелп.
Понравилась статья?
Подпишитесь на наш блог и получайте наши статьи первым!
Или подписывайтесь на нас в соцсетях:
Заметили ошибку? Выделите текст и нажмите одновременно клавиши «Ctrl» и «Enter»
Нашли ошибку?
Текст с ошибкой:
Расскажите, что не так

Бесплатно отвечаем на ваши вопросы. Задайте свой вопрос и получите ответ от профессионального преподавателя. Выберите лучший ответ.
Вопросы могут задавать только авторизованные пользователи. Войти